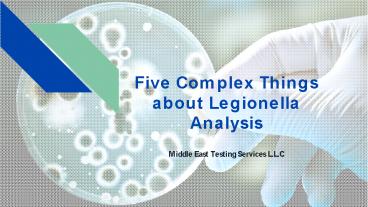

Five Complex Things about Legionella Analysis PowerPoint PPT Presentation
Title: Five Complex Things about Legionella Analysis
1
Five Complex Things about Legionella Analysis
- Middle East Testing Services L.L.C
2
Overview
- Legionella is a kind of bacteria that causes
severe breathing diseases, including pneumonia.
One of the leading causes of a legionella
outbreak could be contamination of conventional
water pipelines. In such cases, it is observed
that due to the lack of proper pipeline
management and cleaning, the outbreak of such
bacteria becomes evident. However, at such times,
conducting a Legionella analysis becomes
imperative. - There are different legionella analyses available
out there. However, as effective as they are,
they can also have a few difficult points about
them. Read on to find more about it!
3
In this method, the legionella bacteria derived
from location samples are isolated on a media
where its growth is supported. Though it is quite
an effective legionella analysis method, there
are a few difficult factors about it.
Culture
01
- It requires a particular media for the bacteria
to grow, such as BCYE Agar. However, not all
laboratories may have it readily available.
02
- It is quite technically challenging.
03
- It is quite a slower process as it requires
around five days to cultivate.
04
- It much depends on the personnel handling the
treatment.
4
Urinary antigen
- Primarily meant for seeking out the symptoms in a
patient, this analysis depends on the detection
of the bacteria within the victims urine. It is
also one of the most common legionella analyses
existing out there. However, even if it is one of
the most common, it still has a few difficult
facts about it
- It can only detect a particular serogroup of the
bacteria (L. pneumophila). - When it comes to environmental isolates, it does
not offer molecular comparisons.
5
Serology
Another methodology used for legionella analysis.
The difficulties in these methodologies are as
follows
- For this analysis, it requires a paired serum
which needs to be collected in between the acute
onset and two weeks, since the visibility of
symptoms. Another set needs to be received after
3-6 weeks. - Because about 5 to 10 of the population has a
titer of 1256, it becomes hard to detect the
bacteria. This is so because it becomes harder to
distinguish between the bacteria and other
pneumonia acquired through the community.
6
PCR (positive polymerase chain reaction)
- Another well sought after analysis for
legionella, this method is rapid and can be used
to detect other serogroups of legionella other
than Lp1. However, it does have one difficulty
- Different laboratories have different assays and
can have limited commercial availability.
7
DFA (Direct Fluorescent Antibody)
- Lastly, this method has become more specific in
recent times. The difficulties one might face
through this method are
- The regents needed for this analysis are a bit
difficult to obtain. - It is more difficult technically, as many labs
might not have the proper equipment for it.
If you suspect a legionella outbreak in your
area, then for the best legionella analysis in
Dubai, get in touch with Metslab for the best
services. Source https//metslab.wordpress.com/20
20/08/04/five-difficult-things-about-legionella-an
alysis/
8
CONTACT US
Middle East Testing Services L.L.C Address Exhib
ition-Showroom No.4, Jurf Industrial Zone 1 Ajman
UAE Phone 971 589505070 / 971 589505077
Website https//metslab.com/